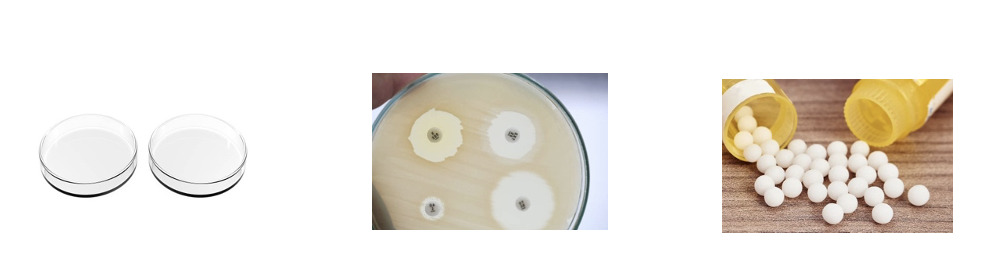
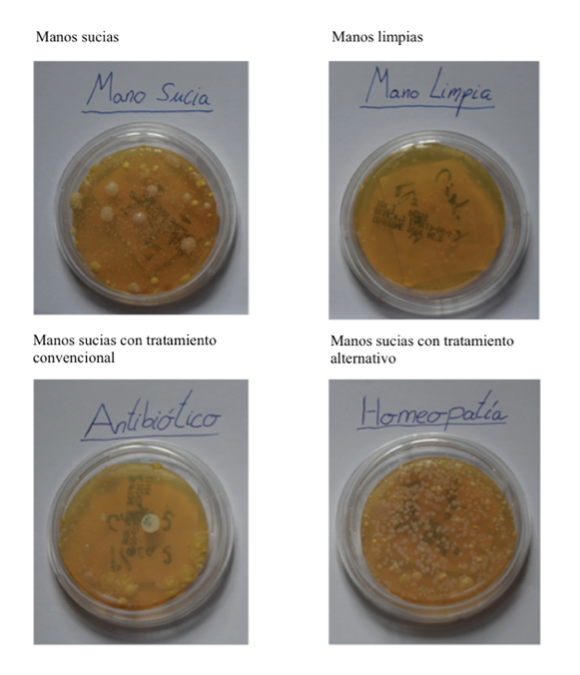

La educación científica hoy
Recepción: 24 Octubre 2022
Revisado: 02 Febrero 2023
Aprobación: 02 Marzo 2023
DOI: https://doi.org/10.25267/Rev_Eureka_ensen_divulg_cienc.2023.v20.i3.3301
Resumen: El pensamiento crítico constituye un elemento esencial en la alfabetización científica cuya importancia ha cobrado un mayor peso en la era de la post-verdad. Invertir esfuerzos en generar diseños didácticos para la práctica de pensamiento crítico es un objetivo esencial de la investigación actual en didáctica de las ciencias. En este artículo se sugiere incorporar un enfoque de enseñanza de pensamiento crítico que involucre la acción en la que se combinen distintos elementos de la práctica y de la metacognición. En base a los resultados de un proyecto sobre pensamiento crítico en la enseñanza de ciencias se presenta: 1) un análisis de las distintas visiones/concepciones sobre pensamiento crítico y sus implicaciones para la enseñanza; 2) argumentos para el desarrollo de pensamiento crítico en contextos relacionados con la post-verdad y principales desafíos; 3) nuestra visión sobre la enseñanza de pensamiento crítico y claves para su aplicación en el aula y, finalmente, 4) un ejemplo de diseño para la práctica de pensamiento crítico fruto del trabajo conjunto de investigadoras/es y docentes de secundaria.
Palabras clave: Pensamiento crítico, era de la post-verdad, problemáticas socio-científicas, enseñanza de ciencias.
Abstract: Critical thinking is an essential component of scientific literacy that has raised its importance in the Post-truth Era. Investing efforts in developing teaching designs for the practice of critical thinking is a main goal of current research in science education. This article suggests integrating a critical thinking teaching approach that involves action in which elements of the practice and metacognition combine. Based on the results of a project on critical thinking in science instruction, we present: 1) an analysis of the different views/conceptions of critical thinking and their teaching implications; 2) arguments for critical thinking development in contexts related to post-truth era and the main challenges; 3) our vision about critical thinking instruction and key points for its application in the classroom; 4) an example of design for the practice of critical thinking developed as a result of the joint work of researchers and secondary school teachers.
Keywords: Critical thinking, post-truth era, socio-scientific issues, science education.
Introducción
Afrontar los desafíos globales del siglo XXI requiere de una ciudadanía crítica capaz de encontrar soluciones a problemas complejos que no siempre se pueden prever, así como de lidiar con la incertidumbre (Dillon y Avramidou, 2020). Muchos de los problemas a los que nos enfrentamos hoy en día cumplen estas características, como ha puesto en evidencia la pandemia de la COVID-19.
El programa PISA 2024 (Organización para la Cooperación y el Desarrollo Económicos [OCDE], 2020) hace hincapié en la importancia de conectar la ciencia con los intereses del alumnado, logrando formar “consumidores y productores críticos de ciencia” para apoyar la agencia en un mundo cambiante. Todo ello conlleva usar metodologías de enseñanza que permitan al alumnado poner en práctica el pensamiento crítico (PC) en el abordaje de problemas socio-científicos como los relacionados con los desafíos de la post-verdad. El PC constituye uno de los objetivos cruciales de los sistemas educativos, siendo una competencia clave incluida en el Marco Europeo de Referencia (Diario Oficial de la Unión Europea, 2018) y en el nuevo marco curricular de educación secundaria (Real Decreto Enseñanzas Mínimas, 2022) en el que el PC se integra dentro de las nuevas competencias específicas vinculadas a disciplinas científicas como Biología y Geología y Física y Química.
El PC es objeto de estudio en distintos ámbitos; desde la filosofía, psicología y la educación. En educación y en la investigación educativa, el PC ha sido utilizado desde hace más de veinte años. Pero, es partir del 2015, tras la publicación de la Agenda 2030 para el Desarrollo Sostenible, cuando esta noción cobra mayor importancia para la investigación y los/las diseñadores del currículo de todo el mundo, ya que se trata de una competencia clave para poder dar respuesta al cumplimiento de los objetivos de desarrollo sostenible.
Desde este marco, la enseñanza de ciencias desde edades tempranas hasta niveles educativos superiores debe integrar el PC (Partnership 21st Century Skills, 2017). Sin embargo, a pesar de que existen evidencias de que el alumnado es capaz de poner en práctica el PC desde edades tempranas, cuando participa, por ejemplo, en procesos relacionados con las prácticas científicas (Bargiela et al., 2022); todavía, son escasas las investigaciones empíricas en esta y otras etapas educativas. La investigación sobre el desarrollo de PC mediante prácticas científicas en aulas de ciencias, línea en la que se enmarca este trabajo, tiene un largo camino por recorrer.
En las últimas décadas se han impulsado las investigaciones sobre cuestiones socio-científicas para promover el PC (Ruiz et al., 2013), pero estos estudios son poco concluyentes respecto a cuáles son las condiciones que estimulan la práctica de pensamiento crítico. Este escenario genera preguntas como: ¿qué ambientes de aprendizaje y enfoques de enseñanza resultan idóneos para fomentar el PC frente a problemáticas socio-científicas? ¿qué características han de tener las tareas para la activación de conocimientos y destrezas de pensamiento crítico? ¿cómo es la práctica de PC en estos contextos?
La visión de PC que presentamos en este trabajo coincide y amplía la presentada por Deanna Kuhn (2019), quien considera el PC una práctica dialógica cuyo desarrollo implica procesos de argumentación que forman parte de las prácticas científicas de indagación y modelización en contextos que implican el establecimiento de un juicio razonado. El PC es una competencia compleja que incluye una serie de componentes relacionados con el juicio razonado y otra serie de componentes relacionados con la práctica ciudadana. Por lo tanto, su desarrollo no puede limitarse al contexto de la argumentación, sino que debe de ir más allá, mediante la acción crítica (Jiménez-Aleixandre y Puig, 2022). Esto implica promover la práctica democrática en el aula, en la que los/as estudiantes sean coinvestigadores/as del conocimiento con el objetivo de poder ser no sólo consumidores críticos, sino también productores críticos capaces de construir conocimientos y tomar acciones que ayuden a resolver problemáticas que les afectan.
Este artículo tiene como fin exponer nuestra visión y propuesta de enseñanza de PC en contextos relacionados con los desafíos de la post-verdad, fruto de la revisión de la literatura científica y el desarrollo de investigaciones en el marco de un proyecto de investigación sobre PC y prácticas científicas. Se presentan los antecedentes, principales características y la importancia de la integración del PC en la enseñanza de estas cuestiones, siendo objetivos específicos de este artículo:
1) Analizar las distintas visiones sobre PC y sus implicaciones.
2) Exponer los principales argumentos para integrar la enseñanza de PC en contextos socio-científicos relacionados con la era de la post-verdad y desafíos existentes
3) Proponer nuestra visión de PC y claves para su aplicación en el aula de ciencias.
4) Compartir diseños basados en la investigación para el ejercicio de PC elaborados por investigadores/as con docentes del proyecto.
Visiones sobre PC e implicaciones para su enseñanza
El PC es una noción compleja cuya definición varía dentro las distintas corrientes de pensamiento como la psicología, educación, filosofía. Durante décadas esta noción ha sido objeto de debate en cuanto a formas de definirlo, tanto en términos teóricos como empíricos (Kuhn, 2019). El panel Delphi de la Asociación Americana de Filosofía (Facione, 1990), en la que participaron 47 expertos de PC de distintas áreas, logró establecer una definición consensuada de PC en la que se incluyeron seis destrezas y a posteriori, siete características acordes con las disposiciones de PC (Facione, 2000). Entender el PC como un conjunto de destrezas y disposiciones puede ser útil a la hora de formular objetivos de enseñanza orientados al desarrollo de esta competencia, sin embargo, de acuerdo con S. Norris (1992), es necesario poder medir/evaluar su desarrollo. Algunas teorías del PC consideran crucial la disposición para pensar, y este autor sugiere llevar a cabo investigaciones empíricas para poder comprobar esta cuestión. Norris destaca que para poder alcanzar uno de los objetivos educativos, promover el desarrollo de PC, es necesario que los teóricos (filósofos) se impliquen más en la investigación empírica (Jiménez-Aleixandre y Puig, 2012).
Según Benderson (1990), las distintas definiciones de PC comparten dos características esenciales: 1) la evaluación o juicio (Facione, 1984): el PC es el desarrollo y evaluación de argumentos; 2) la inclusión tanto de habilidades como de hábitos o disposiciones en su conceptualización. Uno de los trabajos más influyentes sobre PC en educación, “Critical Thinking in Education” (McPeck, 1981, p.8) define el PC como “una disposición y habilidad para participar en una actividad con escepticismo reflexivo”. Pero hemos de preguntarnos: ¿El PC puede definirse como un atributo individual? ¿o implica una actividad social y por lo tanto se desarrolla en interacción con los demás?
Desde la perspectiva de la psicología del desarrollo, D. Kuhn reconoce la necesidad de dos componentes de PC, las capacidades y las disposiciones, aunque critica algunas de sus características. En un trabajo reciente (Kuhn, 2019), la autora enfatiza que el PC más que una habilidad individual, constituye una práctica dialógica en la que se involucran las personas, inicialmente de forma interactiva, y después de forma interiorizada con el resto de manera implícita. Del trabajo de D. Kuhn destacamos la forma en que conceptualiza las destrezas de PC (thinking skills), como una actividad social o algo que la gente realiza de manera cooperativa y que forma parte del discurso (Kuhn, 2005). Esta noción de PC prevalece en la mayoría de la literatura en didáctica de las ciencias que aborda el PC. Autores como Winch (2006) argumentan que las habilidades de PC se relacionan con la capacidad de una persona para desarrollar opiniones y apoyar estas. El mismo autor sostiene que la autonomía, rasgo central de la vida contemporánea, es equivalente al PC. Según Jiménez Aleixandre y Puig (2022), casi todas las definiciones de PC tienen en cuenta las dimensiones relacionadas con el compromiso con las pruebas (argumentación), sin embargo, las dimensiones relacionadas con la participación y la justicia social- lo que se relaciona con el desarrollo de una ciudadanía responsable-, no están presentes, al menos de forma explícita. Consideramos que ser pensador/a crítico/a en el siglo XXI requiere no sólo cuestionar cual es nuestro lugar en el mundo, sino ser capaz de llevar a cabo acciones críticas basadas en el pensamiento racional e independiente a la hora de abordar problemas complejos que nos afectan, como puede ser la actual pandemia de la COVID-19.
Una de las características consensuadas de PC es que requiere de un conocimiento específico del contexto para poder evaluar conocimientos o creencias específicas (Anderman et al., 2012). Estos autores destacan que incluso en ambientes que son favorables para el desarrollo de PC, la falta de conocimiento puede comprometer su desarrollo. Esta cuestión cobra importancia en la actual era de la post-verdad, en la que parece confundirse ser pensador/a crítico/a con criticar, siendo necesario estar informado para poder ejercitar el PC. Además, añadimos a este problema, el hecho de ser un término ampliamente utilizado en el lenguaje coloquial y en los medios, no siempre de manera adecuada, puesto que tiende a utilizarse en el sentido de escepticismo hacia los demás y no hacia uno mismo, cuando ser “pensador crítico” implica ser capaz de cuestionar nuestros estilos de vida, así como de mirar e interpretar con gafas críticas la realidad sin ser manipulado por los valores e ideas dominantes. La capacidad para desafiar las ideas de tu propio grupo (clase) o de la autoridad, no puede ser entendida como una falta de consideración a los distintos puntos de vista, sino que implica la evaluación cuidadosa de la información proporcionada por las diferentes fuentes, de los supuestos que hay detrás de ellas y las pruebas que los sustentan.
El PC implica desarrollar estas habilidades, directamente relacionadas con la inclinación a buscar pruebas nuevas y a considerarlas. Ser capaz de cambiar de opinión en base a las pruebas, aunque esta sea contraria a la idea mayoritaria, forma parte del PC (Puig y Uskola, 2021), y puede ejercitarse mediante diseños socio-científicos donde la componente reflexiva se incorpore, aunque teniendo en cuenta no sólo la dimensión cognitiva, sino también la afectiva.
Entendemos que el PC implica no solo pensar de manera razonable, sino también de “manera independiente”. En otras palabras, la formación de una opinión informada que integre razonamiento científico y valores, así como un PC independiente para la acción social (Jiménez-Aleixandre y Puig, 2022). Esto es particularmente relevante para los procesos de creación de opinión en un mundo multicultural y conectado donde el sensacionalismo y la inmediatez de la información desafían la capacidad de poner en perspectiva la propia opinión y las distintas reacciones emocionales ante estas.
Enseñanza de PC mediante contextos socio-científicos en la era de la post-verdad. Retos y desafíos educativos
El PC es una competencia compleja que puede estimularse en el aula de ciencias mediante el abordaje de cuestiones socio-científicas, como señala la investigación en este ámbito (Hodson, 2003; Solbes, 2013). Estas cuestiones han sido, y continúan siendo utilizadas en la enseñanza de ciencias con el fin de generar ambientes didácticos que ayuden al alumnado a valorar la importancia de la ciencia en sus vidas (Stuckey et al., 2013) y a tomar conciencia crítica frente a problemáticas globales que nos afectan y que requieren del compromiso y participación ciudadana. Son numerosas las investigaciones que muestran los beneficios de integrar la enseñanza de estas cuestiones para el desarrollo de la práctica de argumentación (Albe, 2007), que forma parte del pensamiento crítico, y aplicación de conocimientos científicos (Sadler, 2004). Pese a ello, la enseñanza de ciencias en muchos niveles educativos sigue reduciéndose a una mera transmisión de la información de forma neutral, puesto que, entre otros motivos, el profesorado no se siente lo suficientemente preparado para abordar estos temas, que implican conocimientos de distintas disciplinas, así como lidiar con las tensiones y conflictos de valores que suelen aparecer en los debates (Osborne et al., 2013) e incertezas que los caracterizan (Kampourakis, 2018).
Sumado a todo esto, la cantidad de información y desinformación a la que estamos expuestos pone más difícil al profesorado la tarea de enseñar PC en estos contextos. Con las recientes transformaciones tecnológicas y sociales, los límites entre la verdad, la ficción y la desinformación deliberada son cada vez más difíciles de diferenciar y manejar por parte de la ciudadanía. La aceptación generalizada de afirmaciones infundadas como la idea de que las vacunas causan autismo o que el cambio climático no existe son preocupantes. Si bien, el verdadero conocimiento es un bien colectivo, el conocimiento defectuoso o engañoso puede ser un peligro, tanto individual como colectivo (Osborne et al., 2022). De acuerdo con estos autores, la idea de que las vacunas son dañinas pone en peligro no sólo la vida de quienes sostienen esta idea, sino de toda la comunidad, que depende de un alto porcentaje de vacunados/as para asegurar su salud. En este contexto de auge de noticias falsas y falta de tiempo para poner en perspectiva las distintas opiniones, cabe preguntarse ¿a qué desafíos nos enfrentamos en la enseñanza de PC en la era de la post-verdad? ¿qué problemáticas son urgentes por “el daño social que conllevan” y, en consecuencia, hemos de priorizar en la enseñanza de cuestiones socio-científicas para la acción crítica?
La post-verdad puede definirse como la distorsión deliberada de una realidad con la intención de crear y modelar la opinión pública e influir en las actitudes y valores sociales. En la era de la post-verdad los hechos y las pruebas tienen menos influencia que las referencias a emociones y a creencias personales. Esto tiende a aumentar a medida que las sociedades avanzan tecnológicamente, ya que favorece la transmisión de ingentes cantidades de información que, a menudo, vienen condicionadas por factores e intereses económicos (Valladares, 2020). En lo relativo a la ciencia, se produce una polarización. Por un lado, la confianza en la ciencia ha disminuido; favoreciendo el rechazo a afirmaciones respaldadas por hechos científicos apoyados en pruebas. Por otro lado, la información errónea y la desinformación, especialmente sobre temáticas sociales, está más aceptada (Feinstein y Waddington, 2020). De esta forma, las personas que se posicionan a favor de las pseudociencias apelando a una serie de mecanismos cognitivos, intuitivos y emocionales consiguen obstaculizar la comprensión científica del público receptor (Boudry et al., 2015).
Otro desafío para el desarrollo de PC es la variedad de visiones de la sociedad acerca de la ciencia. Desde una visión absolutista, en la que la ciencia ofrece una verdad absoluta e inamovible, a otra más escéptica y poco certera, en la que, en su extremo, se situarían las personas que rechazan las ideas basadas en pruebas científicas. En este sentido, las cuestiones socio-científicas son de crucial importancia, ya que implican la confluencia de varios agentes, sociedad y ciencia, con factores culturales, en el proceso de demarcar qué consideran los/as ciudadanos/as, estudiantes, así como personas en cargos públicos, conocimiento científico respaldado por la evidencia de la información pseudocientífica para la toma de decisiones (Herman et al., 2022). A nivel de investigación, son reseñables los trabajos del Special Issue de la revista Journal of Research in Science Teaching acerca de la confianza en la ciencia, en la que se abordan cuestiones epistemológicas y sociales y respuestas educativas basados en la ciencia y la tecnología para abordar la post-verdad en las aulas. Respecto a esto último, coincidimos con Keren (2018) en que no es necesario que el alumnado adopte un rol de expertos/as sino de “outsiders competent”. Así, el objetivo de la enseñanza de ciencias será proporcionar al alumnado una comprensión acerca de los mecanismos de la ciencia, un cuerpo pequeño pero robusto de ideas científicas (Nordine et al., 2021), habilidades para abordar la des y sobreinformación, así como fomentar disposiciones de PC para la acción. Covitt y Anderson (2022) proponen para ello ofrecer al alumnado oportunidades para participar dialógicamente en críticas sociales sobre la incertidumbre de la ciencia. En especial, sobre la utilidad de los hallazgos científicos, a pesar de estar condicionados por ésta. Entender que la ciencia proporciona información que puede variar con el paso del tiempo, limitada a unas condiciones y útil para el contexto particular, es una herramienta clave para abordar cuestiones SSI en la era de la post-verdad, visión que apoyan las autoras.
Una propuesta para la enseñanza de PC y claves para su aplicación en el aula de ciencias
Investigaciones realizadas en el marco de un proyecto europeo sobre PC en educación superior (CRITHINKEDU) muestran que una de las dificultades para su enseñanza reside en la escasa formación del profesorado acerca de cómo promover y evaluar esta competencia (Puig et al., 2019). Para ello, consideramos necesario, antes de nada, disponer de una definición operativa de PC que ayude al profesorado a aplicar esta noción en el aula.
Proponemos utilizar la caracterización (ver Figura 1) de Jiménez-Aleixandre y Puig (2022), en la que el PC incluye una serie de componentes relacionados con el juicio deliberado (argumentación); y otra serie de componentes relacionados con la educación para la ciudadanía, y que integra: la capacidad para desarrollar una opinión independiente y desafiar ideas establecidas social y culturalmente, así como para analizar y criticar discursos que justifican las desigualdades sociales (Fairclough, 1995).
El PC implica no solo pensar de manera razonable, sino también de “manera independiente”. En otras palabras, la formación de una opinión informada que integre razonamiento científico y valores, así como un PC independiente para la acción social. Esto es particularmente relevante para los procesos de creación de opinión en un mundo multicultural y conectado en el que el sensacionalismo y la inmediatez de la información desafían la capacidad de poner en perspectiva la propia opinión y las distintas reacciones emocionales ante estas. Esta dimensión del PC, relacionada con la emancipación social y la educación para la ciudadanía, coincide con lo que Piaget (1950) denominaba “decentration” para describir la habilidad progresiva de un niño/a para situarse fuera de su punto de vista.
La capacidad para desarrollar una opinión independiente y, en particular, de desafiar las ideas socialmente establecidas, entendida no como la falta de consideración de diversas alternativas y puntos de vista, requiere un análisis cuidadoso de la información proporcionada por diversas fuentes y de los supuestos que hay detrás de las pruebas que las apoyan. Además, implica ser capaz de cuestionar las ideas mayoritarias del grupo o comunidad en la que te sitúas, lo que para el alumnado de secundaria puede ser un desafío, ya que en esta etapa ir en contra de lo que la mayoría opine no es nada fácil. Trabajar esta disposición requiere realizar tareas abiertas que permitan al alumnado ser consciente de los posibles puntos de vista y tener en cuenta otros valores sin adherirse necesariamente a ellos (Puig et al., 2022). Por ejemplo, mediante juegos de rol o evaluando informaciones que aporten distintas perspectivas sobre problemáticas complejas como: la ola de incendios en Europa, la pérdida de polinizadores, las predicciones en materia energética para 2060, entre otros temas.
Davies y Barnett (2015) proponen un modelo de PC que integra seis aspectos: 1) habilidades básicas en argumentación crítica: 2) juicios críticos; 3) disposiciones y actitudes de PC; 4) ser crítico/a y acciones críticas; 5) crítica social e ideológica, 6) creatividad o apertura crítica. Según este modelo, el PC contempla tanto una dimensión individual como una dimensión sociocultural, visión que compartimos. Consideramos el PC una actividad dinámica que involucra la movilización de destrezas para llevar a cabo acciones y tomar decisiones de manera individual que afectan a la sociedad, y a su vez influidas por esta y el contexto en el que te sitúes. Por ejemplo, las acciones individuales frente al cambio climático implican una gran variedad de elecciones, como: qué dieta seguir, el uso de energías, el consumo, el transporte, etc. Estas acciones están mediadas por factores socioculturales. Analizar en el aula datos que afectan a la decisión de: qué dieta seguir (Brocos y Jiménez Aleixandre, 2022) permite al alumnado reflexionar acerca de los valores culturales y personales que afectan a sus decisiones, y analizar los factores económicos, políticos, etc., involucrados. Todo esto contribuye a la apertura crítica, es decir, a que el alumnado tome conciencia de la necesidad de tener una actitud abierta frente a problemas complejos como este. Además, es importante atender a la enseñanza “para” y “sobre” el PC (Puig et al., 2021). Esto significa promover el PC mediante tareas que permitan su práctica reflexiva. Por ejemplo, haciendo explícito al alumnado las destrezas y disposiciones que se ponen en juego durante una actividad. Esto significa incorporar el PC como un objetivo didáctico y una competencia a desarrollar. Además, teniendo en cuenta que el PC depende del dominio del conocimiento científico sobre el problema a analizar, y de las creencias que tengamos, las tareas que planteemos deben ayudar al alumnado a ser conscientes de ello. Podemos invitarles a que reflexionen sobre cómo sus decisiones y creencias, por ejemplo, frente a las vacunas, podrían afectar a la salud individual y colectiva. O cómo las acciones que adoptemos en favor del cuidado del medio ambiente repercuten directamente en la salud de los ecosistemas y la salud humana. Esto es especialmente importante en la era de la post-verdad, que amenaza la confianza en la ciencia y el PC (Valladares, 2022), puesto que las afirmaciones basadas en la evidencia pierden legitimidad frente a las afirmaciones negacionistas, por ejemplo, frente al cambio climático.
Un ejemplo de diseño “para” y “sobre” el PC, es la secuencia de aprendizaje elaborada por las autoras sobre el cambio climático y la subida del nivel mar (Puig et al., 2022), en la que se solicita al alumnado que identifiquen qué destrezas de PC han movilizado en las distintas tareas, utilizando para ello la taxonomía de Facione (1990).
Integrar el PC en la enseñanza de ciencias requiere desarrollar tareas que requieran la evaluación de enunciados en base a pruebas, la inclinación a buscar nuevas pruebas, considerarlas, e incluso cambiar de opinión; así como la disposición a tener una postura independiente, basada en razones (Jiménez-Aleixandre y Puig, 2022). Es decir, promover la argumentación socio-científica, siendo la actuación docente clave en este sentido. El/la docente ha de crear un clima de confianza en el aula que dé lugar a la participación y a las discrepancias entre el alumnado y con el/la docente. En estos debates es necesario tener en cuenta, la influencia de factores socioculturales en la consideración de la información científica por parte del alumnado. Hufnagel (2022) destaca el papel de las identidades y emociones en la práctica de PC. La enseñanza de PC no es “prescriptiva”, dado que se integra en el contexto en el que se sitúa el alumnado, en sus historias y experiencias personales (Hufnagel, 2022; Pithers y Soden, 2000), por lo que el/la docente ha de procurar hacer estas explícitas para entender su influencia.
Teniendo en cuenta todo lo anterior, involucrar al alumnado en la práctica de PC requiere visibilizar: (a) los componentes involucrados en la práctica de PC (destrezas o habilidades de PC); (b) los elementos/factores que afectan a su desarrollo (Puig y Jiménez-Aleixandre, 2022). Entender el PC como una práctica situada implica identificar su ejercicio no sólo como una forma de pensar, sino también de “actuar”. Llevar a cabo tareas que involucren tensiones y la toma de decisiones frente a problemas socio-científicos crea oportunidades para el desarrollo de PC para la acción crítica y reflexiva.
En la siguiente sección ofrecemos un ejemplo de diseño sobre cómo fomentar el PC bajo este enfoque.
Un diseño para la práctica PC en la enseñanza de controversias
Presentamos un ejemplo de diseño para el fomento del pensamiento y acción crítica en un contexto socio-científico relevante y relacionado con los desafíos de la era de la post-verdad: la homeopatía.
¿Homeopatía o un medicamento convencional para tratar una infección?
La propuesta aborda el problema del auge de las pseudoterapias, mediante una situación de aprendizaje específica relacionada con el uso de la homeopatía para curar el catarro, una infección vírica que tiende a atribuirse al frío en invierno, cuando suele ser más frecuente.
La actividad se basa en un diseño anterior elaborado por la primera autora en colaboración con docentes (Puig et al., 2020), y mejorada en 2022 (Puig et al., 2022) en el marco del proyecto europeo P2D (Progression and Pedagogy of Design: Contextualizing Design based Pedagogy in Teacher Education Programs) sobre PC en la enseñanza basada en el diseño STEM. En este caso, la propuesta se ha reformulado con el fin de activar destrezas y disposiciones de PC para la toma de decisiones responsable acerca de cómo actuar frente a una infección común como el catarro. Ello implica que ambas componentes del PC, relacionadas con la argumentación y la ciudadanía y práctica social (ver Figura 1) se integren.
En el caso de la primera componente, argumentación, la actividad favorece las destrezas que forman parte del PC según Facione (1990), las cuales se presentan en la tabla 1.
Además, en respuesta al aumento de la desconfianza en la ciencia desde la pandemia de la COVID-19, la tarea requiere que el alumnado reflexione acerca de sus conocimientos sobre la naturaleza de la ciencia, promoviendo así el conocimiento epistémico, como sugiere García-Molina (2015). En particular, cómo se construye el conocimiento científico en base a pruebas, sometiéndose a la evaluación constante, lo que explica su naturaleza dinámica. Respecto a la segunda componente del PC (ver Figura 1), y teniendo en cuenta que las emociones podrían afectar a la práctica de PC en este contexto, la propuesta permite expresar, compartir y reflexionar emociones. Entendemos este proceso como un primer paso para aprender a gestionar las emociones para tomar decisiones valorando su papel en el análisis de problemas de salud. La tarea aborda esta componente atendiendo a estas y otros factores en la toma de decisiones sobre qué tratamiento a emplear ante un catarro.
El PC se trabaja de forma implícita, siendo necesario su desempeño en las tareas; y también de forma explícita, presentando este como parte de los objetivos de aprendizaje a alcanzar, y solicitando al alumnado que analice su propia práctica de PC. Los objetivos de aprendizaje son:
1) Diferenciar la homeopatía de un medicamento convencional mediante el uso de pruebas empíricas aplicando PC.
2) Identificar qué destrezas de PC se ponen en práctica en las distintas tareas.
3) Evaluar qué desempeños de PC se han alcanzado al completar la secuencia.
Para poder identificar qué destrezas de PC es capaz de movilizar el alumnado, proporcionamos a los/las estudiantes la tabla 1 en la que se describen las destrezas de PC, adaptadas de la caracterización de Facione (1990), eliminando la tercera columna.
Tarea 1. ¿Homeopatía o un medicamento convencional?
La tarea parte de la siguiente pregunta: ¿Homeopatía o un medicamento para curar un catarro? Pedimos al alumnado, en pequeños grupos, compartir sus ideas, y a continuación, exponerlas oralmente con el resto del aula. El objetivo es hacer consciente al alumnado de sus conocimientos, valores, creencias y PC sobre este tema. A continuación, solicitamos que cubran por escrito anónimamente, y de forma individual, un cuestionario como este:
1) ¿Qué confianza tienes en la ciencia? Trata de indicar del 0 al 3 (0: no confío nada; 1: confío algo; 2: confío bastante; 3: confío totalmente)
2) ¿Sabes lo que es la homeopatía? Descríbelo con tus propias palabras
3) ¿Consideras la homeopatía una terapia científica? Sí/No. Razona tu respuesta
4) ¿En quién confías más para tratar un problema de salud, en la homeopatía o en la medicina convencional? Razona tu respuesta.
Mediante estas preguntas logramos que el alumnado exprese su nivel de confianza en la ciencia, sus ideas o creencias acerca de la homeopatía, y sus criterios a la hora de considerarla o no como una terapia para abordar problemas de salud.
Tarea 2. Diseñar y realizar un experimento para comparar la homeopatía con un medicamento
En esta tarea planteamos el siguiente interrogante, ¿Podemos comprobar de manera experimental la acción de un complejo homeopático frente a un medicamento? Pedimos al alumnado que en grupos debatan esta pregunta y a continuación, les damos una serie de materiales para que de manera experimental puedan resolver la cuestión anterior. Con el objetivo de poder comparar la acción del medicamento frente al complejo homeopático seleccionamos: un antibiótico de amplio espectro como la amoxicilina y un complejo homeopático que dice actuar frente un gran abanico de síntomas similares al del antibiótico proporcionado. Los materiales proporcionados son 4 placas Petri con cultivo, 1 disco de amoxicilina (antibiótico), 1 pastilla de compuesto homeopático (ver figura 2).
El experimento coincide con el ya descrito en Puig et al. (2022), añadiendo en este caso una serie de preguntas, previas al experimento:
- Con este material, ¿qué creéis que podemos hacer para resolver la cuestión inicial? Tratad de explicar el procedimiento a seguir.
- ¿Necesitamos una muestra control? Si/No. Razona tu respuesta.
- ¿Cuáles son vuestras hipótesis de partida? Enúncialas con tus palabras.
Una vez se ponen en común sus ideas, cada grupo compara sus respuestas y el procedimiento sugerido con el referente a seguir, que requiere: tocar con las manos sucias 3 placas Petri (1 placa control, 2 placas tratadas: una con amoxicilina y otra con el complejo homeopático, que sitúan en el centro de la placa) y con las manos limpias otra placa (control).
Teniendo bien rotuladas las cuatro placas, las colocan en la estufa. De no disponer de estufa en el laboratorio escolar, se pueden guardar en un lugar donde la temperatura sea sobre unos 35-36ºC.
Tarea 3. ¿Recomendarías la homeopatía para tratar un catarro?
Una vez realizado el experimento pedimos que anoten sus observaciones en una tabla como esta y que expliquen lo que observan en cada placa.

A continuación, plantemos esta pregunta: ¿en base a tus observaciones y resultados del experimento, recomendarías la homeopatía o el medicamento a un amigo/a? Pedimos que razonen sus respuestas incluyendo pruebas empíricas basadas en las observaciones realizadas. Los resultados obtenidos se muestran en la figura 3.
Tal y como muestran las imágenes, en la placa de manos sucias con homeopatía emergen un gran número de microorganismos, frente a la que contiene el antibiótico. El alumnado ha de extraer sus propias conclusiones y decidir qué recomendar a un amigo/a.
Tarea 4. ¿Confío más en la homeopatía o en un medicamento convencional?
Esta tarea tiene como objetivo que el alumnado valore sus respuestas a la tarea anterior mediante estas preguntas:
- ¿Coinciden vuestras conclusiones con las hipótesis iniciales? Sí/No. Razona tu respuesta.
- A la vista de los resultados, ¿en quién confío más? ¿En la homeopatía o en el medicamento convencional para tratar un catarro? ¿En qué pruebas empíricas me apoyo? ¿Existen otros aspectos que hayan influido en tu respuesta?
- ¿Ha cambiado tu forma de valorar la homeopatía tras el desarrollo de la tarea?
Tarea 5. ¿Qué aspectos del pensamiento crítico has puesto en práctica en la realización de la actividad?
En esta última tarea buscamos que el alumnado reflexione acerca de su práctica de PC en las distintas tareas. Preguntamos si consideran el PC importante para poder resolver las tareas y qué otros aspectos sociales han intervenido, razonando su respuesta. Para ello, como se muestra en la tabla 3, pedimos que identifiquen qué destrezas consideran que han movilizado, en qué momentos de las distintas tareas, y cuál ha sido la carga de aspectos sociales que consideran, ha influenciado sus respuestas (- nada; + poco; ++ algo; +++ bastante; ++++ mucho). Para ello proporcionamos la tabla 1, que describe las destrezas de PC y solicitamos que cubran una tabla como esta:

En base a los datos que cubren en esta tabla 3, preguntamos de nuevo si el PC ha sido importante o no para el desarrollo de las distintas tareas y qué razonen su respuesta. Cada tarea presenta un contexto distinto, destacando estas dos situaciones: la de recomendar o no la homeopatía (tarea 3) y la de confiar o no en ella (tarea 4). Pretendemos conocer en qué medida existen o no diferencias en cuanto al desempeño de PC en uno y otro contexto y que el alumnado identifique cuáles han sido las destrezas que ha llevado a cabo. Partimos de la premisa, tal y como señalamos en el marco de este artículo, que la práctica de PC puede ser más o menos compleja, en función del contexto y que el alumnado ha de ser consciente de ello. En cuanto a la valoración que han de realizar sobre la influencia de otros aspectos sociales, pretendemos ayudar al alumnado a identificar su emergencia y su posible nivel de influencia en el desarrollo de cada tarea, facilitando o no la práctica de PC.
Reflexiones finales
Entre los desafíos para integrar el PC en la enseñanza de cuestiones socio-científicas en la era de la post-verdad destacamos aquellos relacionados con la falta de confianza en la ciencia, cuyas consecuencias podrían ser irreparables según el tema a tratar. Por ejemplo, la negación del cambio climático, el auge de las pseudoterapias o el movimiento antivacunas podrían conducir a una emergencia ambiental y sanitaria a escala planetaria. Atender a estos desafíos en la educación científica ha de ser una prioridad, lo que el nuevo modelo de currículo de ciencias (Ley Orgánica 3/2020, de 29 de diciembre) facilita incorporando los objetivos de desarrollo sostenible y el pensamiento crítico como elemento transversal en el desarrollo de competencias específicas.
Desde la didáctica de ciencias, sabemos que existen modelos de enseñanza que resultan más efectivos que otros. Por ejemplo, el aprendizaje mediante prácticas científicas en contextos controvertidos resulta eficaz para entender la naturaleza de la ciencia (Crujeiras y Jiménez Aleixandre, 2012) y desarrollar PC. Sin embargo, conocer qué situaciones de aprendizaje estimulan en mayor medida la práctica de PC, de forma consciente, continúa siendo objeto de estudio (Puig et al., 2022). En este artículo argumentamos que desarrollar PC implica no sólo practicarlo, sino tomar conciencia de su importancia y entender cuándo y cómo se ejecuta en una tarea determinada; es decir, la enseñanza “sobre” y “para” el PC. También, hacerles conscientes del papel de las emociones y otros aspectos relacionados con la percepción social que pueden afectar al desarrollo de una opinión crítica independiente a la hora de enfrentarnos a cuestiones socio-científicas. Continuemos investigando cómo mejorar la práctica consciente de PC desde un enfoque que, como señala Jiménez-Liso (2020), permita al alumnado aprender practicando las formas de hacer, hablar y pensar en el aula de ciencias.
Agradecimientos
Este trabajo se desarrolló con fondos FEDER/Ministerio de Ciencia, Innovación y Universidades –Agencia Estatal de Investigación/ Proyecto PGC2018-096581-B-C22, ESPIGA, y forma parte del grupo de investigación RODA (Razonamiento, Discurso y Argumentación, www.rodausc.gal). Al profesorado que ha colaborado en este diseño.
Referencias
Albe, V. (2007). Students’ Argumentation in Group Discussions on a Socio-Scientific Issue. En: Pintó, R., Couso, D. (eds) Contributions from Science Education Research. Springer. https://doi.org/10.1007/978-1-4020-5032-9_30
Anderman, E. M., Sinatra, G. M., y Gray, D. L. (2012). The challenges of teaching and learning about science in the twenty-first century: Exploring the abilities and constraints of adolescent learners. Studies in Science Education, 48(1), 89–117. https://doi.org/10.1080/03057267.2012.655038
Bargiela, I., Blanco Anaya, P., y Puig, B. (2022). Las preguntas para la indagación y activación de Pensamiento Crítico en Educación Infantil. Enseñanza de las Ciencias, 40(3), 11-28. https://doi.org/10.5565/rev/ensciencias.5470.
Crujeiras, B. y Jiménez Aleixandre, M. P. (2012). Participar en las prácticas científicas: aprender sobre la ciencia diseñando un experimento sobre pasta de dientes. Alambique, 72, 12-19.
Benderson, A. (1990). Critical thinking: Critical issues. Educational Testing Service.
Boudry, M., Blancke, S., y Pigliucci, M. (2015). What makes weird beliefs thrive? The epidemiology of pseudoscience. Philosophical Psychology, 28(8), 1177-1198.
Brocos, P., y Jiménez-Aleixandre, M. P. (2022). Social Responsibility and Critical Disposition for Considering and Acting upon Conflicting Evidence in Argumentation About Sustainable Diets. En B. Puig y M.P. Jiménez-Aleixandre (Eds.) Critical Thinking in Biology and Environmental Education (pp. 211-227). Springer.
Covitt, B.A., y Anderson, C.W. (2022). Untangling Trustworthiness and Uncertainty in Science. Sci & Educ, 31, 1155–1180. https://doi.org/10.1007/s11191-022-00322-6
Davies, M., y Barnett, R. (2015). Introduction. In M. Davies y R. Barnett (Eds.), The Palgrave Handbook of Critical Thinking in Higher Education (pp. 1-125). New York: Palgrave Macmillan US.
Diario Oficial de la Unión Europea. (2018). Recomendación del consejo de 22 de mayo de 2018 relativa a las competencias clave para el aprendizaje permanente. https://eur-lex.europa.eu/legal-content/ES/TXT/PDF/?uri=CELEX:32018H0604(01)&from=SV
Dillon, J. y Avramidou, L. (2020). Towards a viable response to COVID-19 from the science education community. JASTE, 11 (2), 1-6. https://doi.org/10.33137/jaste.v11i2.34531
Facione, P. A. (1984). Toward a theory of critical thinking. Liberal Education, 70 (3), 253-61.
Facione, P. A. (1990). Critical thinking: A statement of expert consensus for purposes of educational assessment and instruction. Research findings and recommendations. Millbrae, CA: The California Academic Press.
Facione, P. A., Sánchez, C. A., Facione, N. C., y Gainen, J. (1995). The disposition toward critical thinking. Journal of General Education, 44(1), 1-25.
Facione, P. A. (2000). The Disposition Toward Critical Thinking: Its Character, Measurement, and Relationship to Critical Thinking Skill. Informal Logic, 20(1), 61-84. https://doi.org/10.22329/il.v20i1.2254
Fairclough, N. (1995). Critical discourse analysis. London: Longman.
Feinstein, N. W., y Waddington, D. I. (2020). Individual truth judgments or purposeful, collective sensemaking? Rethinking science education’s response to the post-truth era. Educational Psychologist, 55(3), 155-166.
García Molina, R. (2015). Seudociencia en el mundo contemporáneo. Alambique, 81, 25-33.
Herman, B. C., Clough, M. P., y Rao, A. (2022). Socioscientific Issues Thinking and Action in the Midst of Science-in-the-Making. Sci & Educ, 31(5), 1105-1139. https://doi.org/10.1007/s11191-021-00306-y
Hodson, D. (2003). Time for action. Science education for an alternative future. Int. J. Sci. Educ. 25, 645–670. https://doi.org/10.1080/09500690305021
Hufnagel, E. (2022). Emotional sense-making and critical thinking in the era of post-truth: the case of climate change. En B. Puig y M.P. Jiménez-Aleixandre (Eds.) Critical Thinking in Biology and Environmental Education (pp. 41-54). Cham: Springer.
Jiménez-Aleixandre, M. P. y Puig, B. (2022). Educating Critical Citizens to Face Post-truth: The Time Is Now. En B. Puig y M. P. Jiménez-Aleixandre (Eds.). Critical thinking in Biology and Environmental Education. Facing Challenges in a Post-truth World. Springer. https://doi.org/10.1007/978-3-030-92006-7
Jiménez-Aleixandre y Puig, B. (2012). Argumentation, Evidence Evaluation and Critical Thinking. En B. Fraser, K. Tobin & C. McRobbie (Eds.). Second International Handbook for Science Education, Vol 2 (pp. 1001–1017) Dordrecht: Springer.
Jiménez Liso, R. (2020). Aprender ciencia escolar implica aprender a buscar pruebas para construir conocimiento. En D. Couso, M.R. Jimenez-Liso, C. Refojo, C. y J.A. Sacristán (Coords) (2020), Enseñando Ciencia con Ciencia (pp.53-63). FECYT y Fundacion Lilly. Penguin Random House.
Kampourakis, K. (2018). Science and uncertainty. Sci & Educ, 27(9), 829–830. https://doi.org/10.1007/s11191-018-0019-3
Keren, A. (2018). The public understanding of what? Laypersons’ epistemic needs, the division of cognitive labor, and the demarcation of science. Philosophy of Science, 85(5), 781–792. https://doi.org/10.1086/699690
Kuhn, D. (2005). Education for thinking. Harvard University Press.
Kuhn, D. (2019). Critical thinking as discourse. Human Development, 62(3), 146-164. https://doi.org/10.1159/000500171
Ley Orgánica 3/2020, de 29 de diciembre, por la que se modifica la Ley Orgánica 2/2006, de 3 de mayo, de Educación. (LOMLOE). https://www.boe.es/diario_boe/txt.php?id=BOE-A-2020-17264
McPeck, J. E. (1981). Critical Thinking and Education. Routledge.
Nordine, J., Sorge, S., Delen, I., Evans, R., Juuti, K., Lavonen, J., Nilsson, P., Ropohl, M., y Stadler, M. (2021). Promoting Coherent Science Instruction through Coherent Science Teacher Education: A Model Framework for Program Design. Journal of Science Teacher Education, 32(8), 911-933. https://doi.org/10.1080/104650X.2021.1902631
Norris, S. P. (1992). Bachelors, buckyballs and ganders: Seeking analogues for definitions of “critical thinker”. En H. A. Alexander (Ed.), Philosophy of Education 1992: Proceedings of the Forty-Eighth Annual Meeting of the Philosophy of Education Society (pp. 69–71). Urbana, IL: Philosophy of Education Society.
Organización para la Cooperación y el Desarrollo Económicos [OCDE]. (2020). PISA 2024 Strategic Vision and Direction for Science. https://www.oecd.org/pisa/publications/pisa-2024-assessment-analytical-framework-science-strategic-vision-proposal.htm
Osborne, J., Simon, S., Christodoulou, A., Howell-Richardson, C. y Richardson, K. (2013). Learning to argue: A study of four schools and their attempt to develop the use of argumentation as a common instructional practice and its impact on students. Journal of Research in Science Teaching, 50, 315– 347. https://doi.org/10.1002/tea.21073.
Osborne, J., Pimentel, D., Alberts, B., Allchin, D., Barzilai, S., Bergstrom, C., Coffey, J., Donovan, B., Kivinen, K., Kozyreva. A., y Wineburg, S. (2022). Science Education in an Age of Misinformation. Stanford University, Stanford, CA.
Partnership for 21st Century Learning (2017). 21st Century Skills Early Learning. Framework. Partnership for 21st Century Learning.http://www.p21.org/storage/documents/EarlyLearning_ Framework/P21_ELF_Framework_Final.pdf.
Piaget, J. (1950). The Psychology of Intelligence. Routledge.
Pithers, R. T., y Soden, R. (2000). Critical thinking in education: A review. Educational Research, 42 (3), 237-249. https://doi.org/10.1080/001318800440579
Puig, B., Blanco-Anaya, P., Bargiela, I. M., y Crujeiras, B. (2019). A systematic review on critical thinking intervention studies in higher education across professional fields. Studies in Higher Education, 44(5), 860-86. https://doi.org/10.1080/03075079.2019.1586333
Puig, B., Castiñeiras, D., y Pérez Maceira, J. J. (2020). ¿Tratamientos convencionales o terapias alternativas? Alambique Didáctica de las Ciencias Experimentales, 99, 43-48.
Puig, B., Crujeiras-Pérez, B., Bargiela, I. y Blanco-Anaya, P. (2021). Integration of Critical Thinking and Scientific Practices to Design-Based Pedagogy. En I. Elen (Ed.), Design Based Pedagogy book. Design Based Pedagogical Content Knowledge Across European Teacher Education Programs (pp. 89-128). Ankara: Anı Yayıncılık.
Puig, B. y Jiménez-Aleixandre, M. P. (2022). The Integration of Critical thinking in Biology and Environmental Education. Contributions and Further Directions. En B. Puig y M. P. Jiménez-Aleixandre (Eds.), Critical thinking in Biology and Environmental Education. Facing Challenges in a Post-truth World (pp.269-276). Springer.
Puig, B. y Uskola, A. (2021). Debatir para aprender a pensar críticamente sobre ciencias. Alambique Didáctica de las Ciencias Experimentales, 106, 79-80.
Real Decreto 157/2022, de 1 de marzo, por el que se establecen la ordenación y las enseñanzas mínimas de la Educación Primaria. 2 de marzo del 2022. BOE núm. 52. https://www.boe.es/eli/es/rd/2022/03/01/157/con
Ruiz, J. J., Solbes, J., y Furió, C. (2013). Los debates sociocientíficos: un recurso para potenciar la competencia argumentativa en las clases de física y química [Oral communication]. IX Congreso Internacional sobre Investigación en Didáctica de las Ciencias. Girona, España.
Sadler, T. D. (2004). Informal reasoning regarding socioscientific issues: A critical review of research. Journal of Research in Science Teaching, 41(5), 513-536.
Solbes, J. (2013). Contribución de las cuestiones socio-científicas al desarrollo del pensamiento crítico (II): Ejemplos. REurEDC, 10(2), 148-158. http://dx.doi.org/10.25267/Rev_Eureka_ensen_divulg_cienc.2013.v10.i2.03http://reuredc.uca.es
Stuckey, M., Hofstein, A., Mamlok-Naaman, R., y Eilks, I. (2013). The meaning of ‘relevance’in science education and its implications for the science curriculum. Studies in Science Education, 49(1), 1-34.
Valladares, L. (2022). Post-Truth and Education. STS Vaccines to Re-establish Science in the Public Sphere. Sci & Educ, 31, 1311-1337. https://doi.org/10.1007/s11191-021-00293-0
Valladares, E. (2020). Retos del pensamiento crítico jurídico contemporáneo ante la complejidad de la racionalidad en la decisión judicial. Realidad: Revista de Ciencias Sociales y Humanidades, (156), 165-191.
Winch, C. (2006). Education, Autonomy and Critical Thinking. Routledge.
Información adicional
Para citar este artículo: Puig, B., Blanco-Anaya, P. y Bargiela, I. (2023) Integrar el Pensamiento Crítico en la Educación Científica en la Era de la Post-verdad. Revista Eureka sobre Enseñanza y Divulgación de las Ciencias 20(3), 3301. doi: 10.25267/Rev_Eureka_ensen_divulg_cienc.2023.v20.i3.3301